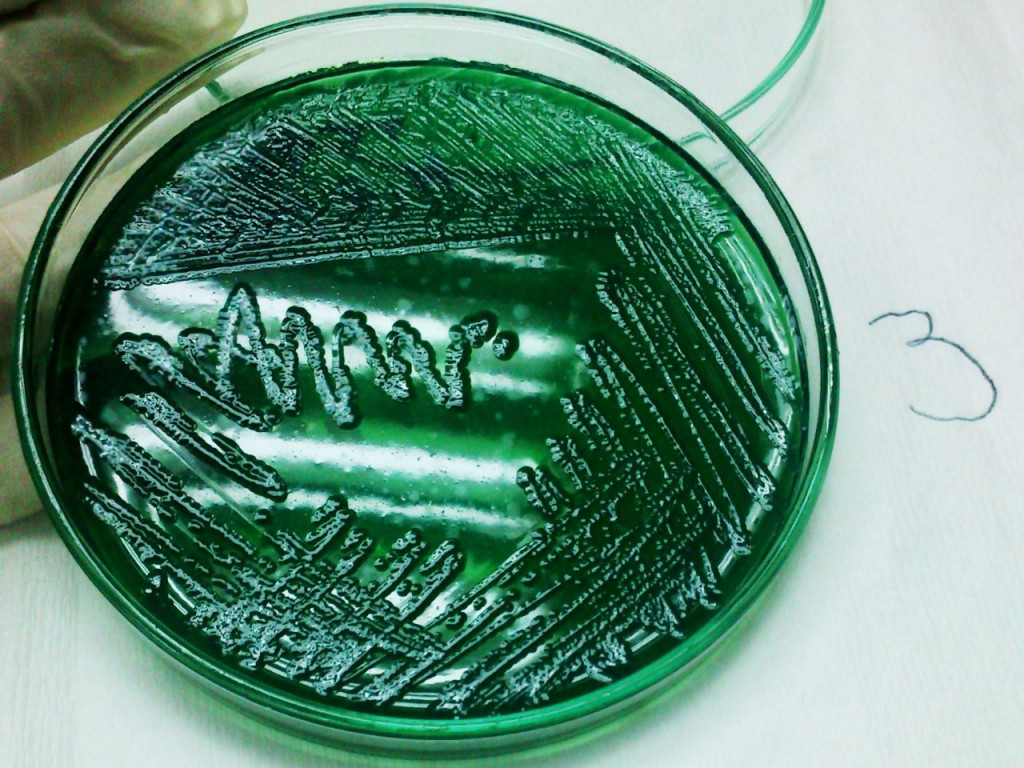

Tần Suất Bổ Sung Carbohydrate Trong Nuôi Tôm Thẻ Công Nghệ Biofloc.
Công nghệ biofloc (BFT) như một giải pháp tiềm năng để cải thiện tính bền vững của ngành nuôi trồng thủy sản. Trong công nghệ này, carbon được thêm vào thông qua việc bổ sung Carbohydrate hữu cơ để cung